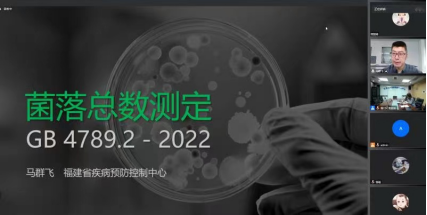

11月8日-10日,2022年食源性病原检测新技术在食品安全风险监测中的应用培训班在南京顺利召开。本次培训班由江苏省疾病预防控制中心食品安全与评价所主办。来自全省各设区市、县(市、区)疾控中心食品微生物检验技术骨干共175人参加了本次培训。江苏省疾病预防控制中心食品安全与评价所副所长乔昕主持开幕式。鉴于当前省内新冠疫情形势,本次培训班采用老师线上授课学员线上学习的形式进行。
乔昕副所长在开幕式上对各位学员在疫情防控任务繁重的当下能够克服困难参加此次继续教育培训表示感谢,同时也对2021-2022年江苏省食品安全风险监测工作完成情况及质量评价进行了报告。
本次培训邀请了国家食品安全风险评估中心风险评估一室主任白莉研究员,对食品微生物风险评估进展特别是应用全基因组测序等监测新技术开展危害识别等风险评估工作做了详细介绍;江西省疾控中心食安所刘洋主管技师以肉糜制品中非伤寒沙门氏菌污染进行了定量风险评估研究方法进展的介绍;福建省疾控中心马群飞主任技师为全体参会学员宣贯并解读了GB 4789.2-2022《食品安全国家标准 食品微生物学检验 菌落总数测定》、GB 8538-2022《饮用天然矿泉水检验方法》等2部2022年新发布实施的检验标准及扩项要点,并根据我省食品安全风险监测需要为各位学员讲授了“副溶血性弧菌检验”、“霉菌酵母计数”等两个食品安全国家标准的检验方法要点、质量控制、方法评审等内容;江苏省疾控中心病原所史智扬主任技师、综合业务办陈敏主任技师分别从微生物生物安全与食品检验检测机构实验室质量管理两个角度对参会人员进行质量管理培训;江苏省疾控中心食安所倪云龙主管技师为学员宣贯了WST799—2022《污水中新型冠状病毒富集浓缩和核酸检测方法标准》,结合省中心食安所开展相关研究与工作的实际评估效果为各参会单位今后开展环境污水中新冠病毒的监测提供了宝贵的经验。
本次培训,内容紧贴实际,丰富详实,受到学员的一致好评。通过本项目的培训促进了本省食品安全风险监测及相关研究技术的发展、增强了全省疾病预防控制系统食源性疾病与食源性致病菌检验专业人员的交流与合作,提高了专业技术人员的理论与实践技能水平,为更好地开展我省食品安全风险监测工作、打造基层食品安全队伍奠定了理论与实践基础。
食安所副所长乔昕主持会议
福建省疾控中心马群飞主任技师在线授课
江苏省疾控中心史智扬主任技师在线授课